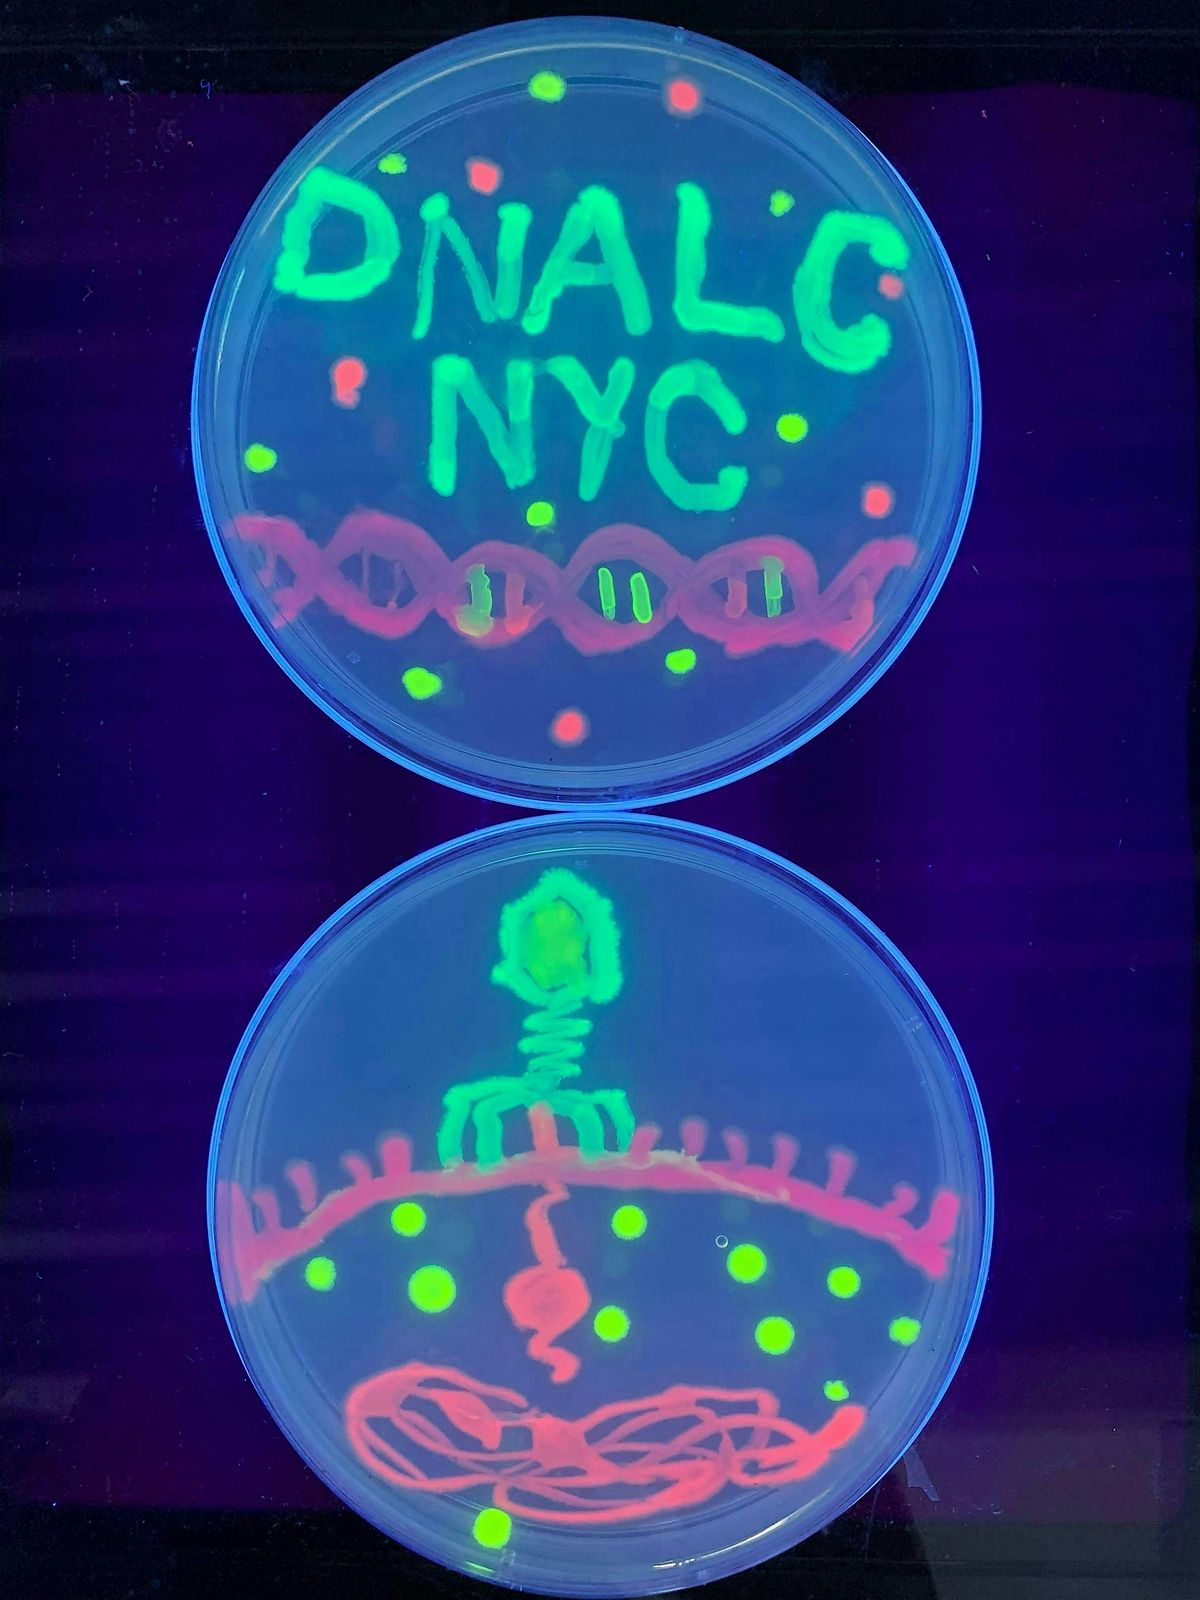

About this Event
Step into the lab and become a scientist for the day! Join us to extract and purify Green Fluorescent Protein (GFP)—a glowing molecule originally found in jellyfish—from genetically engineered bacteria. Then, see how GFP revolutionized biological research and continues to illuminate discoveries in science. To wrap-up the glowing experience, unleash your creativity with agar art—a unique form of “painting” with living bacteria engineered to express vibrant fluorescent proteins. See your artwork come to life under UV light!
In this session, participants will:
- Learn how GFP is used in research;
- Use chromatography to isolate GFP from other cellular proteins;
- Discuss how bacterial cells can be used to produce human proteins;
- “Paint” with colorful bacteria to create “agar art”.
Ages 12 and up. Adult chaperones are not required but welcome to attend (chaperones must purchase their own ticket).
Event Venue & Nearby Stays
Passaic County Technical Institute, John Currie Biotech Innovation Center, 45 Reinhardt Road, Wayne, United States
USD 28.29
